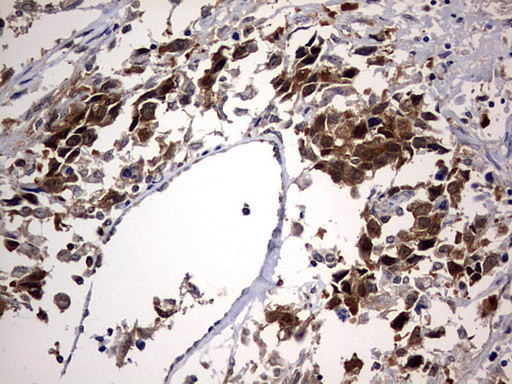
PTGES3 Antibody in Immunohistochemistry (Paraffin) (IHC (P))

Search
OriGene
PTGES3 Monoclonal Antibody (OTI2D2), TrueMAB™
{{$productOrderCtrl.translations['antibody.pdp.commerceCard.promotion.promotions']}}
{{$productOrderCtrl.translations['antibody.pdp.commerceCard.promotion.viewpromo']}}
{{$productOrderCtrl.translations['antibody.pdp.commerceCard.promotion.promocode']}}: {{promo.promoCode}} {{promo.promoTitle}} {{promo.promoDescription}}. {{$productOrderCtrl.translations['antibody.pdp.commerceCard.promotion.learnmore']}}
产品信息
CF803433
种属反应
宿主/亚型
分类
类型
克隆号
抗原
偶联物
形式
浓度
纯化类型
保存液
内含物
保存条件
运输条件
产品详细信息
For reconstitution, we recommend adding 100 µL distilled water to a final antibody concentration of about 1 mg/mL. To use this carrier-free antibody for conjugation experiments, we strongly recommend performing another round of desalting. (Zeba Spin Desalting Columns, 7KMWCO, 0.5 mL, Product # 89882)
靶标信息
Steroid receptors are ligand-dependent intracellular proteins that stimulate transcription of specific genes by binding to specific DNA sequences following activation by the appropriate hormone. Prior to activation, steroid receptors associate with a number of different proteins in both a stable and transient fashion. Steroid receptor complex proteins include heat shock proteins (HSP70 and HSP90), immunosuppressant binding proteins called immunophilins (the FK506 binding proteins, FKBP52 & FKBP54 and the cyclosporin binding protein, CyP-40) and at least three other proteins termed p23, p60 and p48. p23 along with HSP70, HSP90 and p60, combine with progesterone receptor (PR) as members of a transient intermediate complex. Cloned human p23 encodes a protein of 160 amino acids that is highly conserved between species and shows no homology to previously identified proteins. p23 is a highly acidic phosphoprotein with an aspartic acid-rich C-terminal domain and multiple potential phosphorylation sites. In vitro studies have suggested that p23 binds to HSP90 and is necessary for the binding of HSP90 and CyP-40 to PR. While neither its exact function nor mechanism of action have been identified, p23 appears to be an important factor in PR function.
仅用于科研。不用于诊断过程。未经明确授权不得转售。
篇参考文献 (0)
生物信息学
蛋白别名: Co chaperone p23; cPGES; cytosolic prostaglandin E synthase; Cytosolic prostaglandin E2 synthase; Hsp90 co chaperone; Hsp90 co-chaperone; Progesterone receptor complex p23; Prostaglandin E synthase 3; prostaglandin E synthase 3 (cytosolic); Telomerase-binding protein p23; unactive progesterone receptor, 23 kD
基因别名: cPGES; P23; PTGES3; TEBP
UniProt ID: (Human) Q15185
Entrez Gene ID: (Human) 10728